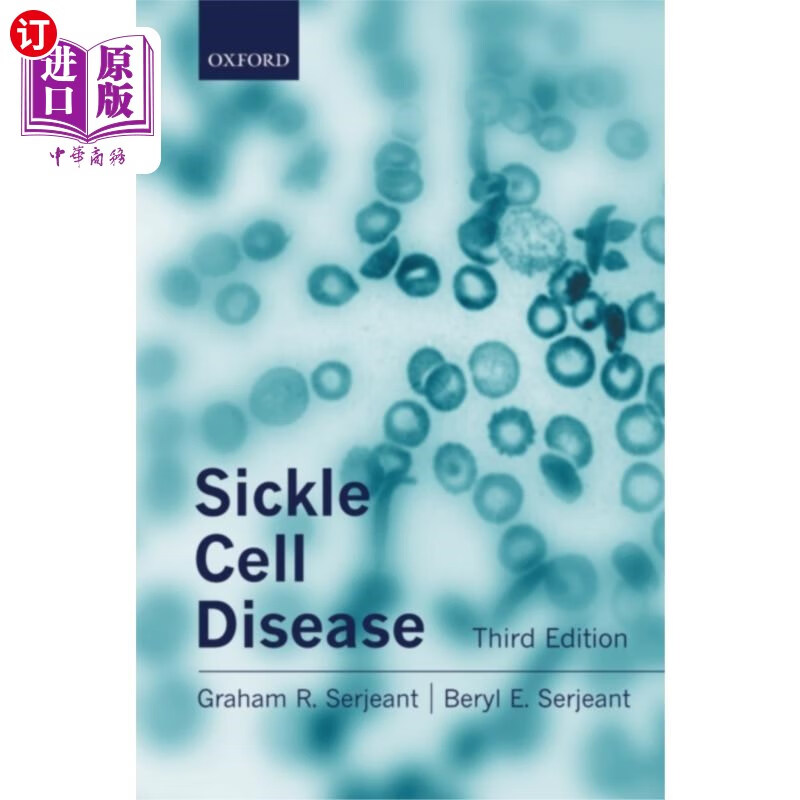
海外直订医药图书sickle cell disease 镰状细胞病

sickle-cell

layers in research, treatment of sickle cell trait and stroke -
图片尺寸670x374
sickle cell 01.jpg
图片尺寸300x480
med surg 42 - blood issues - sickle cell
图片尺寸500x316
sickle cell anemia
图片尺寸500x362
sickle-cell pic
图片尺寸500x373
new options for sickle cell disease
图片尺寸1000x667
sickle-cell
图片尺寸640x354
sss sickle-cell anemia
图片尺寸400x400
treat/cure sickle cell anemia naturally with body oxygen and
图片尺寸1600x1204
【预订】sickle cell anemia
图片尺寸331x500
sickle cell anemia
图片尺寸270x346
sickle cell anemia, 3d illustration showing blood vessel with
图片尺寸1500x1120
sickle cell anemia - a medical dictionary, bibliography, and
图片尺寸270x349
【预售】sickle cell disease
图片尺寸322x420
预订 sickle cell disease
图片尺寸351x499
sickle cell all:layout 1 - ct.gov
图片尺寸357x462
a sickle cell drug reaches a critical readout.
图片尺寸645x645
海外直订医药图书sickle cell disease 镰状细胞病
图片尺寸800x800
cutaneous manifestations of sickle cell disease
图片尺寸1901x1398
【预订】sickle cell disease and hematopoietic
图片尺寸332x500